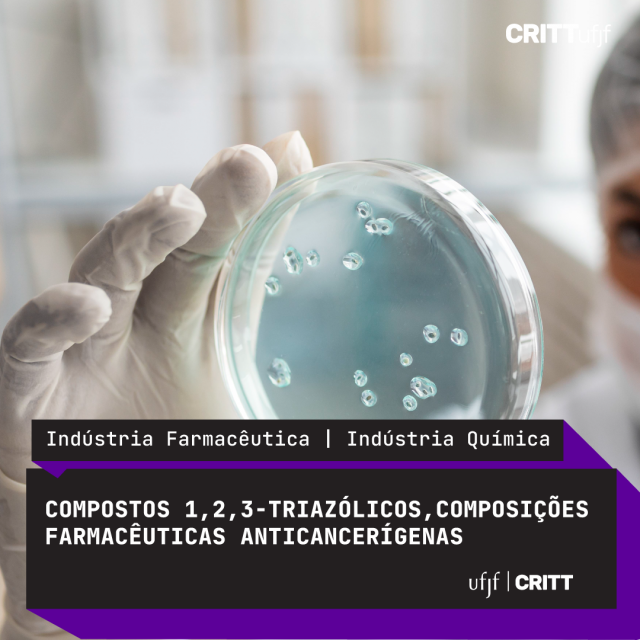

Fármacos para Tratamento de Câncer Cerebral e de Mama
.
.
.
Formulação Despigmentante e Anti-aging
.
.
.
Formulação Farmacêutica Fitoterápica Indicada para o Tratamento da Psoríase
.
.
.
Formulação Antienvelhecimento e Contra Manchas a Base de Ativo Natural
.
.
.
Terapia Natural para o Controle da Dermatite Atópica
.
.
.
Biossensor de Fibra Óptica para Detecção do Antígeno IL-1
.
.
.
Formulação Fitoterápica Dessensibilizante
.
.
.
Formulação de Hidrogel para Prevenção de Infecções Odontogênicas e Bucais
.
.
.
Nanocápsulas para Infecções Orais
.
.
.
Filme Polimérico Bioativo Multifuncional para Lesões Ulcerativas Orais e Sistêmicas
.
.
.
Bioisósteros do Resveratrol Bioconjugados com Esteróides, Antioxidantes
.
.
.
Bioisósteros do Resveratrol Bioconjugados com Esteróides, Antiparasitários
.
.
.
Arilhidrazonas: Agentes Despigmentantes
.
.
.
Estilbenóide Nitrogenado com atividade cosmética, cosmecêutica, farmacêutica e alimentícia
.
.
.
Sal de Triazol e uso como Antioxidante e Citoprotetor
.
.
.
Sal de 1,2,3 – Triazol como Produto Antiparasitário
.
.
.
Fluconazol, nanopartículas de prata e quitosana para combate de candidíase
.
.
.
Caspofungina, nanopartículas de prata e quitosana para combate de candidíase
.
.
.
Anfotericina B, nanopartículas de prata e quitosana para combate de candidíase
.
.
.
.
.
.
Antibióticos, nanopartículas de prata e quitosana em composição antibacteriana sinérgica
.
.
.
Formulação Farmacêutica Fitoterápica Indicada para Dermatites e Psoríase
.
.
.
Formulação Fitoterápica contendo Extrato de Embaúba com Atividade Cicatrizante
.
.
.
Formulação para tratamento de candidíases á base de Mitracarpus frigidus e ciclodextrina
.
.
.
.
.
.
Gel Endodôntico Biocompatível à Base de Quitosana e Carvacrol
.
.
.
Filme Bioativo Natural para Feridas Cutâneas
.
.
.
.
.
.
Filmes de Quitosana com Alecrim
.
.
.
Curativo Cicatrizante de Jabuticaba
.
.
.
Curativo multifuncional de Jambu
.
.
.
Composto de Cobalto com Ação Antileishmania
.
.
.
Fitocomplexo de Lantana camara para Leishmaniose
.
.
.
Nanoestruturas de Jabuticaba com ação fotoquimioprotetora.
.
.
.
Gel Íntimo de Graviola para Candidíase
.
.
.
.
.
.
Gel Vaginal Fitoterápico para Candidíase
.
.
.
Subprodutos da Jabuticaba: Fitocomplexo Anti-inflamatório e Antioxidante
.
.
.
Compostos antimicrobianos associados a terapia fotodinâmica para lesões de pele ou orais
.
.
.
Compostos 1,2,3-triazólicos, composições farmacêuticas anticancerígenas
.
.
.
Iminas Aromáticas Lipídicas com Atividade Cosmética, Cosmecêutica, Farmacêutica e Alimentícia
.
.
Filmes Curativos à base de Quitosana Incorporada de Extrato de Folhas de Coffea Arábica L
.
.
.
.
.
.
Composições Fitoterápicas Nanoestruturadas na Base Bryophyllumpinnatum (LAM) OKEN
.
.
.
Nanopartículas Magnéticas com Duplo Revestimento
.
.
.
Composições Inseticidas Nanoestruturadas
.
.
.
.
.
.
Formulação Fitoterápica de Extrato de Embaúba e Ora-por-nobis
.
.
.
.
.
.
.
Creme Dermatológico Contendo Extrato Etanólico de Vernonia Polyanthes com Efeito Cicatrizante
.
.
.
Formulação para Tratamento de Candidíase Orofaríngea
.
.
.
.
.
Tem interesse em conhecer um pouco mais sobre alguma dessas tecnologias? Entre em contato conosco:
:: Email: att.critt@ufjf.br
:: Telefone: (32) 2102-3435 – Ramal: 204